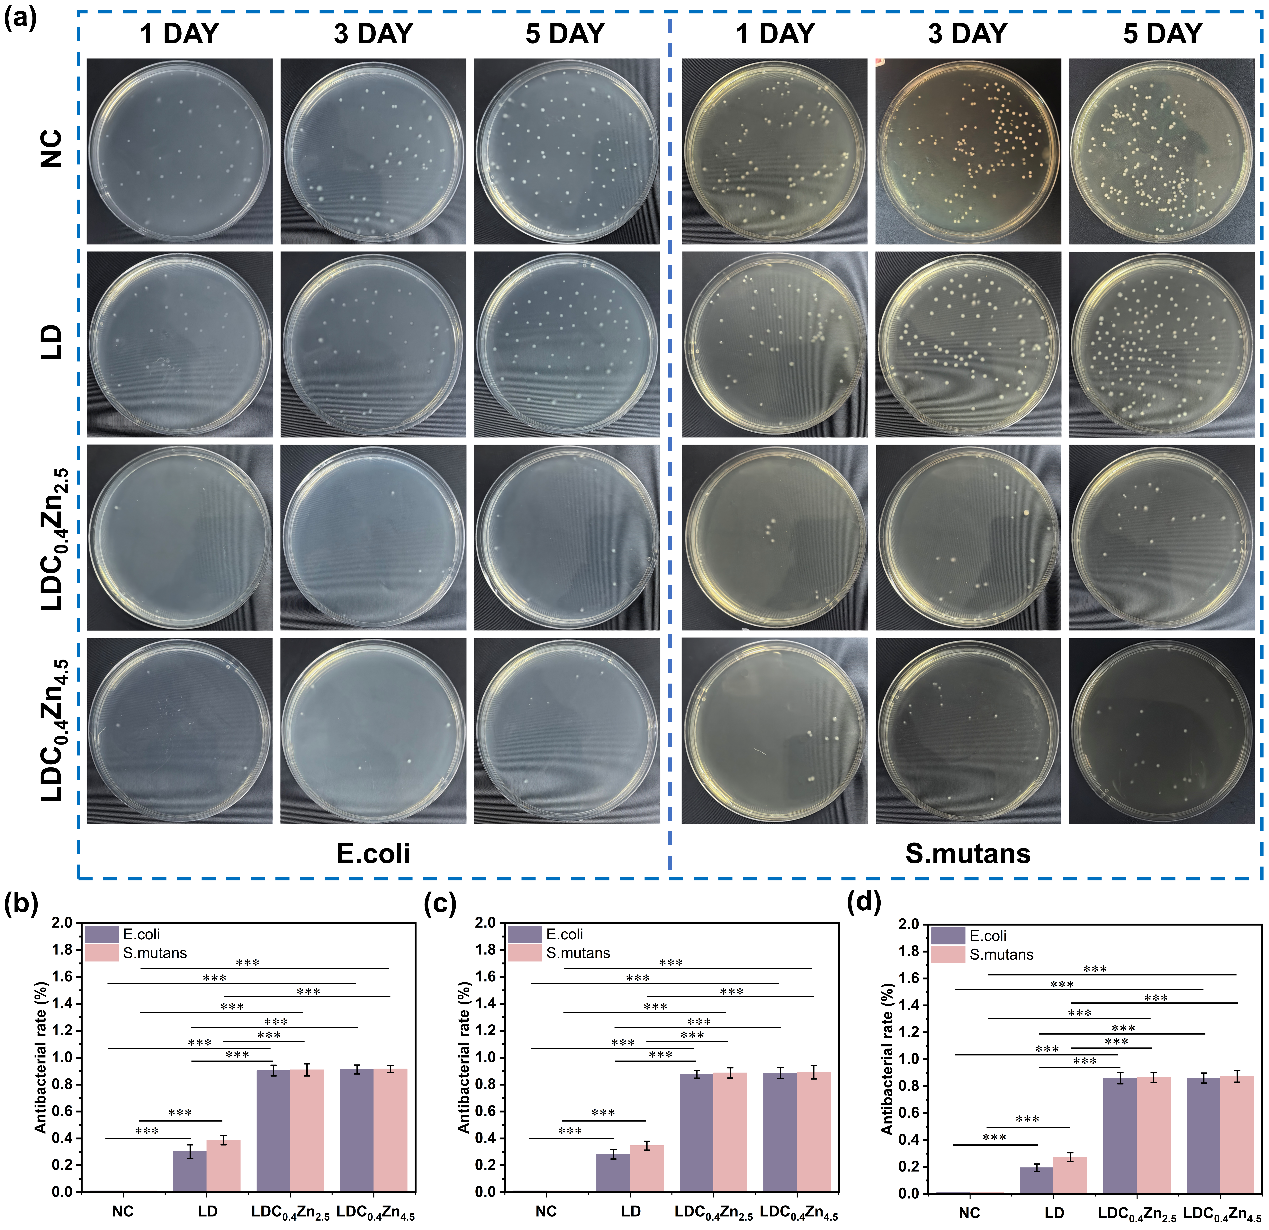
image007.png

精选
||
原文出自Journal of Advanced Ceramics (先进陶瓷)期刊

Cite this article:
Zhang F, Zhang Y, Kang J, et al. Composite powder design strategy enabling vat photopolymerization 3D printing of lithium disilicate glass-ceramics with high precision, strength, and antibacterial properties. Journal of Advanced Ceramics, 2026, https://doi.org/10.26599/JAC.2026.9221253
文章DOI:10.26599/JAC.2026.9221253
1、导读
硅酸锂玻璃陶瓷因半透明性、高强度、生物相容性优异被广泛应用于牙科修复。相比传统粉末烧结与机械加工,光固化3D打印可显著提升生产效率与材料利用率,但其材料的半透明特性导致光散射严重、精度不足,制约工艺发展并引发修复不密合、继发龋等问题。本研究基于光散射原理提出功能复合粉末设计策略,调控浆料光学性能实现高精度成形并赋予抗菌功能,为推进功能化牙科陶瓷3D打印的临床应用奠定基础。

2、研究背景
为提高制造效率、降低成本,陶瓷3D打印技术被广泛使用和研究。但二硅酸锂玻璃陶瓷的半透明特性在光聚合中引发严重光散射,导致打印精度下降,进而造成修复体与牙体不密合、细菌渗漏及继发龋等临床风险。目前,改善半透性陶瓷材料打印精度的策略主要集中于优化工艺参数、改善陶瓷浆料流变特性以及调控粉体折射率,但这些方法尚存在精度提升有限、工艺复杂、成分残留等问题。
本研究围绕材料的光学参数以及光的散射特性,提出了复合粉末设计策略(玻璃粉/碳粉/氧化锌),引入高消光系数的碳粉作为光吸收剂,降低光散射以提升精度;低消光系数、折射率匹配树脂的氧化锌粉,增强纵向光穿透以保证固化深度,同时利用其抗菌特性赋予修复体长期抑菌功能,实现精度-强度-抑菌协同优化。
3、文章亮点
(1)提出复合粉末设计策略,综合调控消光系数和折射率,解决光散射以及碳粉对光过量吸收的难题,为半透性材料玻璃陶瓷的光固化3D提供普适性解决方案。
(2)通过硅酸锂、碳粉与氧化锌协同,同时提升“精度-强度-抗菌”三大性能,满足牙科修复体在口腔环境服役可靠性、预防继发性龋齿等综合需求。
4、研究结果及结论
图1为浆料的复合设计。碳粉利用其高消光系数抑制光散射,且在高温下可完全氧化挥发,故被选为光吸收剂。氧化锌则通过三重机制发挥作用:其折射率与树脂匹配,可补偿碳粉过度吸收导致的光穿透不足;同时促进烧结致密化;并凭借自身抗菌特性赋予材料抑菌功能。样品按组分及含量命名:LD代表纯二硅酸锂基体;LDCx表示添加x wt%碳粉;LDCxZny表示在LDCx基础上再添加y wt%氧化锌。

图1 浆料的配方:(a) LD组浆料的配制;(b) LDCX 组浆料的配制;(c) LDCXZny组浆料的配制
图2对比了不同组别的光散射模拟结果。均质树脂因无折射率差异而不产生散射;引入半透明玻璃粉后,其与树脂的折射率失配导致严重光散射,导致严重的散射和过大的固化深度和宽度。碳粉的加入通过对散射光的强吸收显著降低了散射,这种过度的吸收会导致欠固化和层间结合差。相比之下,C和ZnO的共掺杂(图2d)得到了更平衡的结果。

图2 光散射模拟结果:(a)未填充树脂;(b)含有微晶玻璃颗粒的浆料;(c) LDC0.4组的浆料;(d) LDC0.4ZnO2.5组的浆料
图3中总结的打印精度实验结果证实了有限元模拟预测的趋势。结果表明,该方法使硅酸锂的打印误差降低92%,且氧化锌的添加改善了试样的层间结合。

图3 (a) LDCx的单层打印尺寸误差;(b) LDC0.4Zny的单层打印尺寸误差;(c) LD、LDC0.4、LDC0.4Zn2.5和LDC0.4Zn4.5的精度孔试样打印尺寸误差;(d) 紫外线照射能量对LDCx浆料固化深度的影响; (e) 紫外线照射能量对LDCxZny浆料固化深度的影响;(f-g) 3D打印的精度孔试样。
图4对比了各组别的力学性能,与LD相比,LDC0.4Zn2.5试样强度提高43.1%,抗弯强度达297.28 MPa,断裂韧性为3.74 MPa·m1/2,优于多数现有DLP打印二硅酸锂材料。

图4 (a)载荷-位移曲线,(b)抗弯强度和弹性模量,(c)维氏硬度和断裂韧性,(d)微晶玻璃的孔隙率。
氧化锌的引入赋予材料持续抗菌功能。对大肠杆菌与变形链球菌的抗菌率长期稳定在85%以上,满足牙科修复体在口腔环境中预防继发性龋齿的需求。
图5 材料的抗菌性。(a)变形链球菌和大肠杆菌与不同材料的共培养结果。(b)共培养一天后的抗菌率。(c)共培养三天后的抗菌率。(d)共培养五天后的抗菌率。
5、作者及研究团队简介

张凡(第一作者),济南大学机械工程学院硕士研究生,主要研究方向为硅酸锂玻璃陶瓷3D打印。

王高琦(通讯作者),济南大学教授/博导,山东省高校青年创新团队负责人。主要研究方向为医疗器械增材制造技术及装备、表面功能涂层等。兼任中国机械工程学会摩擦学分会青年委员,《Additive Manufacturing Frontiers》、《摩擦学学报》青年编委。主持国家自然科学基金面上项目/青年项目等科研项目10余项。以第一或通讯作者在Additive Manufacturing Frontiers、Additive Manufacturing、 Tribology International 、Journal of Manufacturing Processes、Journal of the European Ceramic Society等高水平期刊发表SCI收录论文30余篇,授权国家发明专利20余件,获得省部级科研奖励3项。
作者邮箱:me_wanggq@ujn.edu.cn
作者ORCID:0000-0003-2926-0642
《先进陶瓷(英文)》(Journal of Advanced Ceramics)期刊简介
《先进陶瓷(英文)》于2012年创刊,清华大学主办,清华大学出版社出版,清华大学新型陶瓷材料全国重点实验室提供学术支持,创刊主编为中国工程院院士、清华大学李龙土教授,主编为中国科学院院士、清华大学林元华教授、苏州国家实验室周延春教授、广东工业大学林华泰教授和哈尔滨工业大学张幸红教授。该刊主要发表先进陶瓷领域的高质量原创性研究和综述类学术论文,涉及先进陶瓷的制备、结构表征、性能评价的各个细节,尤其侧重新材料研制和先进陶瓷基础科学研究等重要方面,致力于在世界先进陶瓷领域搭建学术交流平台,引领和促进先进陶瓷学科的发展。已被SCIE、Ei Compendex、Scopus、DOAJ、CSCD等数据库收录。现为月刊,2025年发文量为202篇;2025年6月发布的影响因子为16.6,连续5年位列Web of Science核心合集“材料科学,陶瓷”学科33种同类期刊第1名;2024年11月入选“中国科技期刊卓越行动计划二期”英文领军期刊项目;2025年入选中国科学院文献情报中心期刊分区表材料科学1区Top期刊。2023年起,本刊结束与国际出版商的合作,改由清华大学出版社自主研发、拥有自主知识产权的科技期刊国际化数字出版平台SciOpen独家发布,标志着该刊结束多年来“借船出海”的办刊模式,回归本土独立运营,也是我国优质英文期刊中最早回归国产平台的期刊之一。
期刊主页:https://www.sciopen.com/journal/2226-4108
投稿地址:https://mc03.manuscriptcentral.com/jacer
期刊ResearchGate主页:https://www.researchgate.net/journal/Journal-of-Advanced-Ceramics-2227-8508

Archiver|手机版|科学网 ( 京ICP备07017567号-12 )
GMT+8, 2026-3-20 12:47
Powered by ScienceNet.cn
Copyright © 2007- 中国科学报社